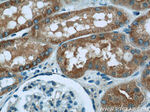
TOM70 Antibody in Immunohistochemistry (Paraffin) (IHC (P))

Search
Proteintech
TOM70 Polyclonal Antibody
{{$productOrderCtrl.translations['antibody.pdp.commerceCard.promotion.promotions']}}
{{$productOrderCtrl.translations['antibody.pdp.commerceCard.promotion.viewpromo']}}
{{$productOrderCtrl.translations['antibody.pdp.commerceCard.promotion.promocode']}}: {{promo.promoCode}} {{promo.promoTitle}} {{promo.promoDescription}}. {{$productOrderCtrl.translations['antibody.pdp.commerceCard.promotion.learnmore']}}
产品信息
14528-1-AP
种属反应
已发表种属
宿主/亚型
分类
类型
抗原
偶联物
形式
浓度
规格
纯化类型
保存液
内含物
保存条件
运输条件
产品详细信息
Immunogen sequence: KNREPLMPS PQFIKSYFSS FTDDIISQPM LKGEKSDEDK DKEGEALEVK ENSGYLKAKQ YMEEENYDKI ISECSKEIDA EGKYMAEALL LRATFYLLIG NANAAKPDLD KVISLKEANV KLRANALIKR GSMYMQQQQP LLSTQDFNMA ADIDPQNADV YHHRGQLKIL LDQVEEAVAD FDECIRLRPE SALAQAQKCF ALYRQAYTGN NSSQIQAAMK GFEEVIKKFP RCAEGYALYA QALTDQQQFG KADEMYDKCI DLEPDNATTY VHKGLLQLQW KQDLDRGLEL ISKAIEIDNK CDFAYETMGT IEVQRGNMEK AIDMFNKAIN LAKSEMEMAH LYSLCDAAHA QTEVAKKYGL KPPTL (245-608 aa encoded by BC052994)
靶标信息
Functional mitochondria require up to 1000 proteins to function properly, with 99% synthesized as precursors in the cytoplasm and transported into the mitochondria with the aid of cytosolic chaperones and mitochondrial translocators (import components). Proteins to be imported are chaperoned to the mitochondria by the cytosolic heat shock protein (cHSP70) and are immediately pursued by Translocators of the Outer Membrane (TOMs), followed by transient interactions of the unfolded proteins with Translocators of the Inner Membrane (TIMs). TOMM70A is ubiquitously expressed in human tissues and localizes in the mitochondria. TOMM70A could play a significant role in the import of nuclear-encoded mitochondrial proteins with internal targeting sites such as ADP/ATP carriers and the uncoupling proteins.
仅用于科研。不用于诊断过程。未经明确授权不得转售。
生物信息学
蛋白别名: FLJ90470; Mitochondrial import receptor subunit TOM70; Mitochondrial precursor proteins import receptor; Translocase of outer membrane 70 kDa subunit; translocase of outer mitochondrial membrane 70 homolog A; Translocase of outer mitochondrial membrane protein 70; unnamed protein product
基因别名: 2610044B22Rik; D16Ium22; D16Ium22e; D16Wsu109e; KIAA0719; mKIAA0719; TOM70; TOMM70; TOMM70A
UniProt ID: (Human) O94826, (Mouse) Q9CZW5, (Rat) Q75Q39
Entrez Gene ID: (Human) 9868, (Mouse) 28185, (Rat) 304017